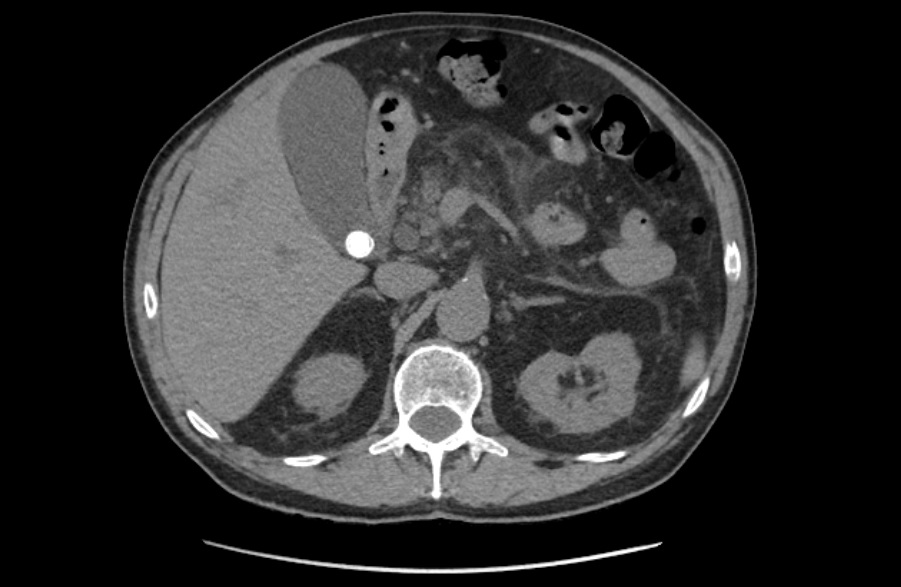

X Jornadas de Actualización en Medicina de Urgencias y VI Jornadas de Ecografía de la semFYC
6-7-8 de febrero de 2025
Enfoque individual: antecedentes personales, anamnesis, exploración, pruebas complementarias, etc.
Hombre de 70 años, fumador de 5 cigarros/día, hipertensión en tratamiento. Acude a Urgencias por dolor epigástrico de 2 meses, irradiado hacia ambos hipocondrios y espalda, con reagudización en los últimos 20 días. No náuseas ni vómitos. Ritmo intestinal mantenido. No ictericia ni acolia, sí coluria. Astenia e hiporexia marcadas, pérdida de 2 kg en el último mes. No fiebre.
Exploración física: No ictericia. Abdomen blando y depresible. Dolor a la palpación en hipocondrio y flanco derechos, donde se palpa una masa indurada de bordes nodulares. No signos de irritación peritoneal.
Analítica sanguínea: Leucocitos 11,83 miles/mm3. Coagulopatía leve. Alteración de novo del perfil hepático con datos de citolisis y colestasis (Bilirrubina Total 1.80 mg/dL, Fosfatasa alcalina 1128 U/L, GGT 784 U/L, GOT/AST 335 U/L).
Ecografía clínica a pie de cama: Parénquima hepático y esplénico de ecoestructura preservada. Vesícula biliar marcadamente distendida con imagen hiperecogénica de 2 cm en porción declive compatible con litiasis. Dilatación de la vía biliar intrahepática difusa así como dilatación del colédoco.
Juicio clínico, diagnóstico diferencial, identificación de problemas
La litiasis y la dilatación de la vesícula biliar encontrada en la ecografía clínica no justificaba todo el cuadro, por lo que solicitamos ecografía reglada al equipo de radiología. En ella informan marcada dilatación de la vía biliar intrahepática, con un colédoco de hasta 15 mm, y estructura mamelonada de aproximadamente 7 cm en cabeza pancreática. Se completa estudio con Tomografía Axial Computarizada que confirma masa en cabeza pancreática compatible con adenocarcinoma que condiciona dilatación de la vía biliar retrógrada.
Tratamiento y planes de actuación.
Analgesia intravenosa durante su estancia en Urgencias. Contactamos con Digestivo de guardia para valoración.
Evolución
Ante el buen estado general del paciente, y tras consensuarlo con él, se decide alta con observación domiciliaria e ingreso programado para continuar estudio.